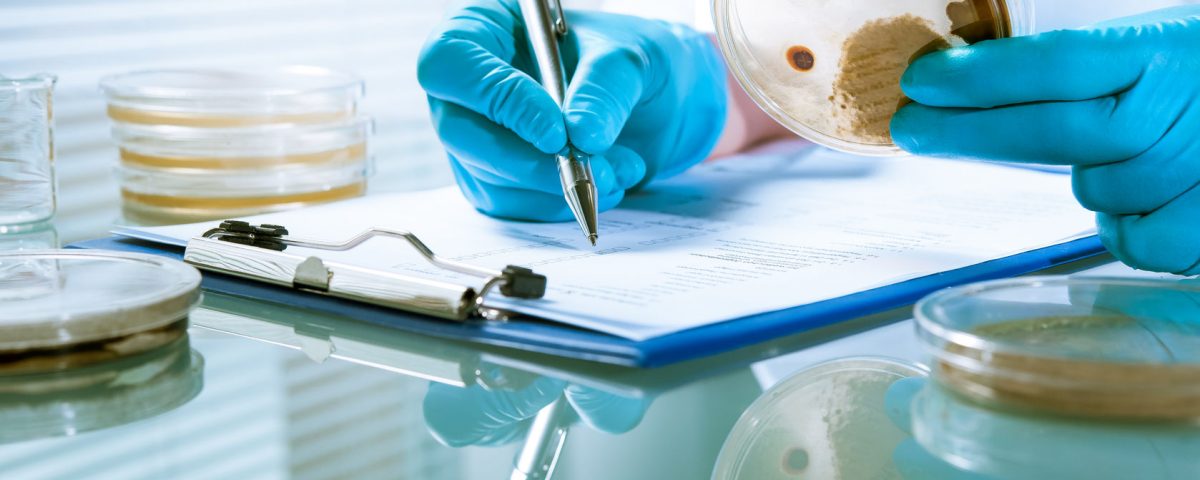

- World's No.1 selling Anti Bacterial Treatment System!
- +971 56 3304466
- +971 55 9676070
- info@bactakleen.ae
How long must an object soak in a disinfection solution?

How to disinfect house after hand, foot, and mouth disease
February 9, 2021
Everything You Should Know about Pfizer Vaccine within the UAE and Dubai
February 9, 2021Cleaning is not a chore that many people enjoy doing, but it’s necessary. And as the number of harmful microorganisms continues to grow, disinfection has also become an important activity that should be incorporated into the daily cleaning routine (Wong et al. 2017). With the ongoing pandemic, the world has familiarized itself with the importance of hygiene, which involves cleaning and disinfecting the things we use regularly.
You go out to public places, like work or even a grocery store, and while you are there, you try your best to avoid bringing the virus home with you upon your return. You clean and sanitize your hands as instructed by the health experts, but most people ask: how can I be sure that my clothes are not carrying the virus? The answer to that question is, there is no way of knowing.
The WHO and CDC hygiene guidelines recommends that the best approach is to clean and disinfect your clothes as soon as possible. Apart from coronavirus, other pathogens are clinging to your clothes, and washing alone cannot kill them; you need a disinfection solution. So the question is, for these pathogens to be eradicated, how long must you soak these clothes in a disinfection solution?
The amount of time it takes to rid your soaked garments of pathogens
There is usually a dwell time or kill time, which means the time required by a disinfectant to eliminate all pathogens. These kill times vary depending on the disinfectant you are using, but we focus on bleach in this case. It takes approximately 10 minutes minimum for a disinfection solution to kill pathogens (Gharpure et al., 2020). Before you commence your cleaning activity, ensure that the room is well ventilated and use appropriate personal protective equipment.
High-level disinfection will require a ratio of 1/3 cup of household bleach to one-gallon water, and then you soak your laundry for a minimum of 20 minutes. And if you are targeting to remove tough stains like maybe blood or body fluids from the garment, use a ratio of 1 ¾ cups of bleach to one gallon of water. However, it’s important to note that bleach can be inactivated by organic matter, so you’ll need to wash the object first and then soak it to remove the residue of bloodstains, body fluids, etc. It is meant to revert the garment to its original state or color and kill pathogens simultaneously.
Wilkinson et al. (2018) pointed out that it is essential to follow the recommended dilution instruction without assumptions. Don’t think that over-concentration of the disinfection solution will work better; it can cause corrosion and irritation, which is not suitable for your health. Over-diluted concentration is less effective, meaning you’ll only be throwing money down the drain without results. The best option is to follow the instruction given.
Soaking other objects
Here is another issue of dwell time, soaking other objects, floors, and surfaces will require 10 to 15 minutes max, then dry. However, other object materials like stainless steel may require proper rinsing with clean water to prevent corrosion (Wong et al., 2017). Utensils also require adequate rinsing. When doing your cleaning chores, try and change the disinfection solution when it becomes cloudy. And finally, you should avoid mixing disinfectant solutions with other chemicals, not even a detergent, unless stated otherwise by the manufacturer. A disinfectant solution must be discarded after use.
References
Gharpure, R., Hunter, C. M., Schnall, A. H., Barrett, C. E., Kirby, A. E., Kunz, J., … & Garcia‐Williams, A. G. (2020). Knowledge and practices regarding safe household cleaning and disinfection for COVID‐19 prevention—United States, May 2020.
Wong, J. P. S., Carslaw, N., Zhao, R., Zhou, S., & Abbatt, J. P. D. (2017). Observations and impacts of bleach washing on indoor chlorine chemistry. Indoor Air, 27(6), 1082-1090.
WHO Guidelines on Hand Hygiene in Health Care (Advanced Draft) Global Patient Safety Challenge 2005–2006. (2009). Clean Care is Safer Care, 2009. Geneva, Switzerland: WHO Press. Available at https://www.who.in/atientsafet/nformation_centr/ast_April_versionHH_Guidelines%5B3%5D.pdf
Wilkinson, MAC et al. (2018) Comparison of the efficacy and drying times of liquid, gel and foam formats of alcohol-based hand rubs. Journal of Hospital Infection 98, 359–64.